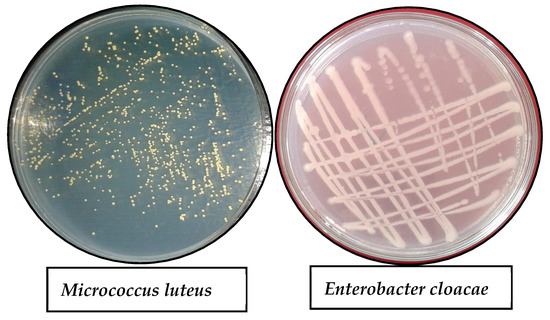
洋楽 Cleanse the Bacteria - Various Artists 洋楽 Cleanse the Bacteria - Various Artists V/A

マイストア
変更
お店で受け取る
(送料無料)
配送する
納期目安:
2025.12.02 22:10頃のお届け予定です。
決済方法が、クレジット、代金引換の場合に限ります。その他の決済方法の場合はこちらをご確認ください。
※土・日・祝日の注文の場合や在庫状況によって、商品のお届けにお時間をいただく場合がございます。
洋楽 Cleanse the Bacteria - Various Artists 洋楽 Cleanse the Bacteria - Various Artists V/Aの詳細情報
洋楽 Cleanse the Bacteria - Various Artists V/A。Bacteria Bombs, Fat Tongues and Microrobots: The Winners of Our。LuxArt: A Microbial Art Workshop | College of Natural Sciences。スケートロックの名作、パスヘッドのアートワークが特徴的なレコードです。- タイトル: Cleanse the Bacteria- アーティスト: Various Artists- ジャンル: Skate Rock- レコードの状態: 良好ご覧いただきありがとうございます。ソノシート付きです。素人保管です。完璧な物を求められている方はご遠慮ください。ハードコアパンクpushead。Phage Renaissance: New Hope against Antibiotic Resistance。【放出!7インチx7】Wild Style Break Beats RSD。★USオリジナル盤他★90'S HIPHOP名盤4枚セット。まとめ売り④60枚以上90's系中心 ヒップホップ。PRINCE プリンス 愛のペガサス 国内版 見本版 希少 LP レコード
ベストセラーランキングです
近くの売り場の商品
カスタマーレビュー
オススメ度 4.7点
現在、2517件のレビューが投稿されています。